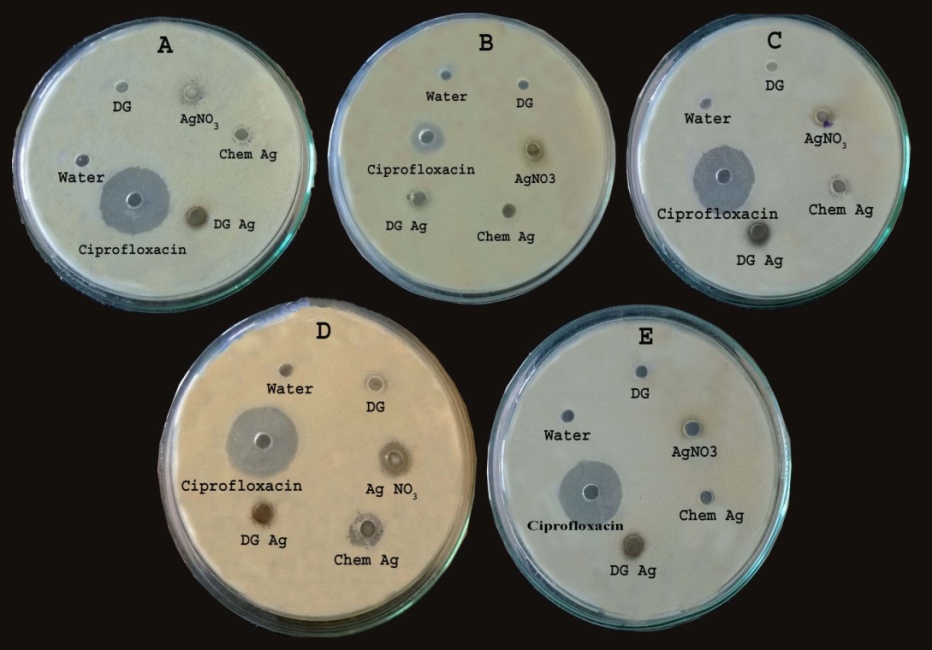

Vascular Biology Laboratory, School of Chemical and Biotechnology, SASTRA University, Thanjavur, Tamil Nadu.
Email: ginokurian@hotmail.com
Received: 07 Nov 2014 Revised and Accepted: 05 Dec 2014
ABSTRACT
Objective: The rapid progress in nanotechnology was always accompanied by their toxic impaction the environment and human health, which creates an urge for researchers to find an alternative approach. In the present work, silver nanoparticles (AgNPs) synthesized through chemical (hydrazine hydrate) and green (aqueous Desmodium gangeticum root extract) route were compared for their biological activity and toxic behavior.
Methods: AgNPs were characterized by different techniques like UV-Visible Spectrophotometry, X-ray Diffractometry (XRD), Fourier transform infra-red spectroscopy (FTIR), Zeta Analyzer, Thermo Gravimetric Analysis (TGA) and Scanning electron microscopy (SEM). The free radical scavenging potential was measured through DPPH, Superoxide scavenging assay and Total phenol content and antimicrobial activity by disc diffusion method. The cytotoxicity was examined by LDH assay.
Results: Characterization showed no significance change in the nature of nanoparticles prepared. AgNPs prepared by biological method showed high free radical scavenging potential, better antimicrobial activity and less-toxic to epithelial cells.
Conclusion: Bioreducing and biostabilizing properties of the plant makes the synthesized nanoparticles to possess the necessary features to be applied in biological applications.
Keywords: Hydrazine hydrate, Desmodium gangeticum (DG), Silver nanoparticle, Zeta potential, Antimicrobial.
INTRODUCTION
For the past two decades, noble metal nanoparticles (gold, silver, platinum, etc.,) have become the area of focused research due to their unique physicochemical properties viz., electronic [1], optical [2], magnetic [3]and chemical properties [4] which are significant from their macro scaled materials [5]. The unique properties of nanoparticles are attributed due to their small size and the larger surface to volume ratio [6].
Despite of many positive traits in general nanoparticles accumulation in the cells cause toxicity. The rapid expansion of nanotechnology to different fields was also accompanied by insufficient data analysis for their bio-hazard identification. Silver metals and silver salts have been most commonly employed in numerous consumer products that include fabrics, cosmetics, and health care products [7-8]. So far, reported literature suggested that silver can be considered to have no adverse effects on the human body until it reaches above threshold concentration levels. However, there is an obvious lack of information regarding the toxicity of AgNPs at the cellular and molecular level. Few studies reported that AgNPs are highly toxic to various cultured cells. Exposure of AgNPs to cells decreased its cell viability, increased leakage of lactate dehydrogenase (LDH) from the cell. Furthermore, they inhibit mitochondrial function in rat liver cells [9], mouse germ line stem cells [10], human fibroblasts [11]and rat adrenal cells [12]. Thus the demand for ecofriendly and economical AgNPs persists and that paved the way for the green synthetic approach for AgNPs preparation [13].
In the present study, aqueous extract Desmodium gangeticum root was used to synthesize AgNPs due to their reported high antioxidant and reducing potential. It is a widely used plant in an Indian system of Medicine in treating inflammation [14], fever, ischemia reperfusion injury [15], myocardial infarction [16] and other neurological imbalances [17]. Phytochemicalprofile showed the presence of alkaloids, pterocarpnoids, flavonoids in Desmodium gangeticum which supports the reduction of metals into nanoparticles and thereby reduces their toxicity [18].
Recently, our lab had shown that aqueous root extract of DG can be used to prepare TiO2 nanoparticles [19]. In this study, we characterized the silver nanoparticles prepared by both chemical and green route and later were evaluated for their biological action and toxicity.
MATERIALS AND METHODS
Experimental section
In the present study, Desmodium gangeticum (Linn) DC (DG) roots were collected from ST. Berchmanns college botanical garden Changanacherry, Kerala, India, authenticated by HOD Botany Dept., SB College. Silver nitrate (AgNO3), Hydrazine Hydrate was procured from Sigma–Aldrich Chemical Pvt. limited and all chemicals of analytical grade were used.
Preparation of plant extract
One kilogram (1 kg) of fresh secondary roots of DG were sliced and air-dried at room temperature. The sliced, air-dried roots of the plant were milled into fine powder in a commercial blender. The powder was Soxhelt extracted with 2.5 liters of distilled water at 37oC for 24 hours. The combined aqueous extracts were filtered and concentrated to dryness under reduced pressure at 30±1oC. The resulting aqueous extract was freeze-dried, finally giving 18.66 g [i.e., 1.866% yield] of a light-brown, powdery crude aqueous root extract of DG. Aliquot portions of the crude root aqueous extract residue was weighed and dissolved in distilled water (25 mg/ml) for use on each day of our experiment. Preliminary qualitative thin layer chromatography analysis of the aqueous extract showed the presence of alkaloids (Dragendorff’s reagent), flavones (Shinoda test and Uranium acetate test), Phenols (4 amino anti pyrine test) and steroids (para-toluene sulfonic acid test).
Synthesis of silver nanoparticles
Chemical Synthesis of AgNPs
100 ml of silver nitrate (5 mM) was mixed with hydrazine hydrate (400 µl) without adding any capping or stabilization agent. Spontaneous color change was observed from colorless to blackish grey color. The mixture was centrifuged at 2000 rpm for 5 minutes and pellet was rinsed with distilled water. Grey colored particles were dried and stored for further characterization.
Biological synthesis of AgNPs
100 ml of silver nitrate (5 mM) solution was added to 25 ml of DG aqueous extract (1 mg/ml) heated for 30 min at 80˚C with continuous stirring. The formation of silver nanoparticles was observed by a color change from brown to reddish yellow black. The mixture was centrifuged at 2000 rpm for 5 minute and the pellet was rinsed with distilled water. Black colored particles were dried and stored for further usage.
Characterization of silver nanoparticles
The optical properties of prepared silver nanoparticles were evaluated in 10 mm pathlength quartz cuvette using Perkin-Elmer Lambda 2 Spectrophotometer, in the wavelength range of 300-800 nm. Crystalline nature and phase of synthesized silver nanoparticles were determined from XRD peak broadening using Rigako instrument, which was operated at a voltage of 40 kV and a current of 30 mA with CuKα target radiation (1.5405 Å). Size, morphology and distribution of particles were examined using scanning electron microscopy (JOEL, Japan Model-6360). FT-IR analysis were carried out for both chemical and DG synthesized AgNPs to study the possible functional groups in the DG extract and hydrazine hydrate reducing agents, which might participate in the reduction process of the Ag+ions and which may surrounds the thus-formed AgNPs to provide stability. The samples were then dried and grinded with KBr pellets and analyzed on the Perkin Elmer FT-IR system Spectrum GX model in the range of 400–4000 cm-1 at a resolution of 8 cm-1 at 25°C. Zeta potential is an essential parameter for characterization of stability in aqueous nanoparticle suspensions. The surface charge and dispersity nature was analyzed using a Zetasizer Nano–ZS (Malvern Instruments). Thermo gravimetric analysis (TGA) is an analytical technique used to determine a material’s thermal stability and its fraction of volatile components by monitoring the weight change that occurs as a specimen is heated. The weight loss spectrum of silver nanoparticles was recorded from room temperature up to 1000 oC with a heating rate 10 oC/min (in the presence of air)using SDT-Q600 model, TA instrument USA.
DPPH, Total phenol assay and superoxide scavenging
DPPH (2, 2-diphenyl-2-picryl hydrazyl), a stable free radical, when acted upon by an antioxidant, is converted into diphenyl-picryl hydrazine with a color change from deep violet to light yellow color measured spectrophotometrically at 518 nm. The free radical scavenging effect of DG extract and silver nanoparticles (chemical and green route)was done using DPPH free radical according to Solver-Rivas et al. (2000), with slight modification [20]. Total phenolic content was quantified using Folin-Ciocalteau reagent in alkaline medium [21]. Superoxide scavenging potential was evaluated according to Winterbourne et al. (1975) method [22]. This assay is based on the inhibition of the formation of nitrobluetetrazolium formazan product of the superoxide ion which can be read spectrophotometrically at 560 nm.
Antimicrobial activity
Well diffusion method [23] was used to check the antimicrobial activity of silver nanoparticles. 25 mL of molten and cooled Mueller Hinton agar were poured in sterilized petri dishes. The plates were left overnight at room temperature to check for any contamination. All the bacterial test organisms were grown in Mueller Hinton broth for 24 hours. The 100 µl nutrient broth culture of each bacterial organism was used to prepare bacterial lawns in petri dishes. Agar wells (8 mm) were prepared with the help of a sterilized stainless steel cork borer. The wells in each plate were loaded with 100 μl of silver nanoparticles, along with the precursor (AgNO3) and DG extract. The inoculated plates were incubated overnight at 37 °C and checked for antimicrobial activity. Ciprofloxacin was used as standard and water as negative control.
Cytotoxic analysis
Cytotoxic behavior of synthesized silver nanoparticles in terms of cellular damage was evaluated by lactate dehydrogenase (LDH) assay [24] in LLC-pk1 epithelial cell line. This assay relies on the release of cytoplasmic lactate dehydrogenase into the medium due to cell injury. Cells were cultured in 96-well plate for 24 hours before treating them with silver nanoparticles, its precursor (AgNO3) and DG extract. After 24 hours of treatment with different test compounds, 50 µl medium was collected and added with the reaction mixture consisting of NAD+(50 µl), phosphate buffer (0.2 M; pH 7.4)and lactate (50 µl) in the same order as mentioned. The absorbance was read immediately at 340 nm for 10-15 minutes.
Statistical analysis
In biological evaluation assays like DPPH, Superoxide scavenging, total phenol and LDH, the data signify the mean±SD of three samples and are representatives of three independent experiments. The data were subjected to analysis of variance (ANOVA) by graph pad prism 5.
RESULTS AND DISCUSSION
Characterization of silver nanoparticles
UV-visible spectral analysis
UV-visible spectroscopy is one of the most widely practiced techniques for structural characterization of nanoparticle. Characterized surface Plasmon resonance for AgNPs prepared by chemical route showed a specific absorption band at λmax 421 nm and for biologically prepared AgNPs, showed the characteristic band at λmax 430 nm [25]. Compared to chemically synthesized AgNPs, biologically prepared nanoparticles were evenly sized and spherical in shape(determined by narrow and single absorption band) as shown in Fig.1A and were stable for over one month (measured by zeta potential) as observed from Fig.3.
XRD diffraction
X-ray Diffraction analysis was performed to determine the phases and crystalline nature of AgNPs. Face centered cubic structure of AgNPs prepared by both methods was confirmed by the XRD pattern as shown in (Fig.1 B and C). Chemically synthesized AgNPs showed sharp Diffraction peaks at 2θ angles of 38.060, 44.240, 64.660 and 77.430corresponding to (111), (2 0 0), (2 2 0), (311)(JCPDS, File No. 4-0783). Diffraction Peaks at 32.80o, 44.04o, 64.34o and 77.28o corresponding to (111), (200), (220) and (311) Bragg’s reflections was observed in biologically synthesized AgNPs. However in addition to the above peaks diffraction spectrum at 27.96o, 38.28o, and 46.18o(denoted by *)] [26]in biologically prepared AgNPs denote amorphous and organic phases. Further observation revealed that the silver nanoparticles prepared by both routes have sharp peaks, which indicate the good crystalline nature, but the diffraction peaks for the biological silver nanoparticles were slightly broadened, due to the smaller crystallite size. The size of the crystallites of Ag was determined from the line broadening of XRD pattern using Scherer formula and was found to be 5.25 nm for AgNPs obtained by chemical method and 1.24 nm for biological mode of preparation.
SEM (Scanning electron microscopy)
The SEM analysis was used to evaluate morphology of both chemical and DG synthesized silver nanoparticles. Fig.2 clearly shows the presence of spherical shaped particles. Part A shows strong aggregation of chemically synthesized nanoparticles in granulate resulting in large, irregular sized particles compared to the green synthesized AgNPs (part B) which might happened due to the lack of stabilizing agent. Also the presence of varying sized particles was observed in case of chemical AgNPs, whereas monodispersed nature of particles was observed in case of green AgNPs (correlates with Zeta analysis which shows PDI of 0.3). Observed nanoparticles were in the range of 30 – 300 nm in diameter for chemical AgNPs and 20 – 25 nm in case of green AgNPs.
FTIR (Fourier transform infra-red spectroscopy)
The interaction between different organic and inorganic functional groups in prepared AgNPs was investigated by FTIR. Fig.1 D and E shows the IR spectra of silver nanoparticles synthesized by chemical and green route in the range of 400-4000 cm-1. The IR spectrum shows absorption bands at wave number (cm-1) 3434, 2923, 2853, 1628, 1384, 1074 for chemically prepared AgNPs (Fig.1 D) which refers to amine or amide N-H stretching of hydrazine hydrate, N-N stretching, NH2 deformation and nitrate stretching [27-28].
Fig.1 E shows the spectra of biologically synthesized silver nanoparticles with sharp peaks at3401, 2925, 2852, 1615, 1384, 1334, 1319, 1048, 596 and 509 cm-1refers to O – H stretching of (phenols or hydroxyl groups), O – H stretching/C=O stretching of carboxylic acids and C=N stretching in aromatic amines. C=N stretching confirmed the presence of phytocompounds present in plants which acts the role of reducing as well as an effective capping agent [29-30].
TGA (Thermo Gravimetric Analysis)
TGA is one of the important tools for material characterization in which the mass of a substance is monitored as a function of temperature. In the present study we used this technique to characterize the prepared AgNPs as TGA is generally used to compare two similar products. Despite of having similarities in AgNPs developed by two methods, TGA results (fig. 1F and G) suggested thermal stable AgNPs by chemical route (5% weight loss), whereas AgNPs obtained by green route are thermo labile (31% weight loss) indicating the presence of phytocompounds such as stigmasterol, genistein, caffeic acid or phenyl ethylamine (reported in the GCMS from previous studies) [31] on the surface of the nanoparticles preventing them from aggregation.
Zeta potential analysis
The surface charge of nanoparticles in the solution and its colloidal stability were usually determined in terms of zeta potential. Fig.3C and Dshowszeta potential spectra for both chemically synthesized (-12.5mV) and biologically synthesized AgNPs (-16.5mV). The overall behavior of the AgNPs in the suspension suggested stable, monodispersed nanoparticles developed by green synthetic route compared to conventional chemical method. A higher level of zeta potential of AgNPs prepared by DG root extract resulted from greater electrostatic forces between the particles that in turn increased the separation between them thereby reduced the possibility of aggregation compared to chemical AgNPs. This was evidenced from the size distribution spectra and poly dispersity index (PDI) of green silver nanoparticles (216 nm and 0.354) and chemical route (419 nm and 0.935) respectively as shown in fig.3 A and B.

Fig. 1: Characterization of silver nanoparticles A) UV-Visible Spectra, B) XRD pattern of chemAgNPs, C) XRDpattern of DG Ag NPs, D) FTIR Spectrum of, E) FTIR Spectrum of DG Ag NPs, F) TGA pattern of chem Ag NPs and G) TGA pattern of DG AgNPs

Fig. 2: Scanning electron micrograph of silver nanoparticles A) Chemical AgNPs; B) DG AgNPs

Fig. 3: Zeta potential analysis A) Size distribution of chemical AgNPs; B) Size distribution of green AgNPs; C) Potential distribution of chemical AgNPs; D) Potential distribution of green AgNPs
Anti-oxidant Assay
Various studies have shown that nanoparticles like fullerenes, carbon nanotubes, emission particles etc., can trigger free radical formation [32]. These radicals can directly develop on the surface of the particles. Assumingly, metal oxide nanoparticles can act as catalyst in the generation of reactive oxygen species. In the present study we used DPPH radical and superoxide radical to assess the scavenging potential of AgNPs (fig. 4A and B). Both DPPH and superoxide radical generated by in vitro method was effectively scavenged by AgNPs prepared by DG aqueous root extract as compared to chemically synthesized route. This difference in their biological activity may be attributed to some special functional groups (identified by FTIR) associated with AgNPs developed by green route. DG root extract is well known for its antioxidant potential and its phytocompounds not only can act as reducing agent for the synthesis of the particles but also act as a stabilizing agent and augment the physical properties suitable for biological applications.
Phenolic content assessment was used to underline the antioxidant potential of AgNPs by green route. Our results (fig. 4C) show higher level of phenolic compounds associated with the nanoparticles prepared by biological method than the nanoparticles from chemical route.

Fig. 4: A) DPPH scavenging assay; B) Superoxide scavenging assay and C) Total phenol content
Antimicrobial Activity
Metal nanoparticles are widely used in industrial applications like paints, cosmetic preparation and to enhance its attributes, recent efforts are founded on antimicrobial behavior against pathogenic bacteria. In the present study we used both gram positive (S. aureus-MTCC 7405) and gram negative (K. pneumoniae-MTCC 9401 P. Aeroginosa-MTCC 7083, P. Vulgaris-MTCC 7299 and V. cholerae-MTCC 3904) bacterial strains to assess bactericidal potential of AgNPs prepared by both chemical and green route by well diffusion method. The diameter of the inhibition zones mediated by AgNPs (Green & chemical), AgNO3 and DG extract (fig. 5)
Fig. 5: Anti-bacterial activity of silver nanoparticles against A) K. pneumoniae-MTCC 9401; B) P. Aeroginosa-MTCC 7083; C) P. Vulgaris-MTCC 7299; D) S. aureus-MTCC 7405 and E) V. cholerae-MTCC 3904)
Was analyzed by Image J software and the results are shown in table I. Zone of inhibition mediated by AgNPs from biological route was prominent as compared to AgNPs synthesized by chemical route. Compared to positive control (ciprofloxacin),
Table 1: Zone of inhibition
| Zone of inhibition diameter (cm) | |
Chemical Ag NPs |
|
| Staphylococcus aureus | 1.012 |
| Klebsiella pneumoniae | 0.61 |
| Pseudomonas aeruginosa | - |
| Vibrio cholera | - |
| Proteus vulgaris | 0.766 |
Bactericidal activity of AgNPs was low indicating the stability of AgNPs, as interaction of silver ions and bacteria is a pre-requisite for antimicrobial action. It was postulated that interaction of silver ions with thiol (S–H) group in enzymes and proteins in bacteria mediates its destruction [33]. These stable AgNPs nanoparticles can be used for various biomedical applications such as drug delivery, bio-implants, etc.
Toxicity
Silver nanoparticles, one of the man-made nanoparticles, widely used in commercial medical and consumer products is not devoid of toxicity issue. There is no confirmed evidence to show the AgNPs themselves exert particle specific toxicity. In the light of these observations, we made a comparative evaluation towards the toxic nature of silver nanoparticles prepared by both green and chemical routes through LDH activity. Our results show less toxic potential of AgNPs prepared by green route (fig. 6). The phytocompounds on the surface of the green Ag nanoparticles augments the stability resulting in less damage to the cells. Evidences from previous studies indicate that regardless of their physical parameters viz., shape, size, etc., AgNPs exhibits their toxicity which depends on the concentration of the released silver ion under aerobic condition. Hence the low toxicity of biologically synthesized nanoparticles may be due to the controlled release of Ag+through controlling the oxygen availability [34].

Fig. 6: Cytotoxicity of silver nanoparticles in LLC-pk1 cells – LDH assay
CONCLUSION
In this study, we compared the synthesis approach taking into account both green route and chemical route. The silver nanoparticles synthesized by green route exhibits similar physico-chemical characteristics as compared to the chemically synthesized ones. But green
AgNPs were found to have better colloidal stability; higher antioxidant potential and significant bactericidal activity as compared to the chemical AgNPs. Finally, the biologically synthesized silver nanoparticles were found to causeless cell damage. Overall results shows the significance of the usage of plant as reducing agent as it possess both bioreducers and biostabilizers which makes the synthesized nanoparticles to possesses the above required characteristics for biological applications.
ACKNOWLEDGEMENT
The authors greatly thank SASTRA University for providing laboratory facilities and also acknowledge Dr. P. Brindha, Assosciate Dean, CARISM (Centre for Advanced Research in India Systems of Medicine), SASTRA University for her support and generous assistance.
CONFLICT OF INTERESTS
Declared None
REFERENCES